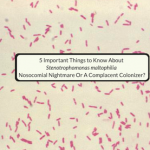

In this article a pharmacist with specialized training in infectious diseases discusses five key areas of study to master in the field of antimicrobial pharmacotherapy, to become an antibiotic ninja. Authored By: Timothy P. Gauthier, Pharm.D., BCPS, BCIDP Article posted 11 October 2022 It is commonplace for learners such as students and residents to … [Read more...]
Why Is Nobody Using Your Guidelines? – Insights On Designing Useful Guidelines For Infectious Diseases
In this article an expert in clinical information design provides his insights, discussing reasons why some guidelines do not get used along with solutions to these problems. Interview with: Michael Long, Ph.D. Interview by: Timothy Gauthier, Pharm.D., BCPS, BCIDP Article Posted 2 September 2022 Recently The Joint Commission released an update to … [Read more...]
Antimicrobial Stewardship in the United kingdom: Perspective From A Pharmacist At A Bone & Joint Hospital
In this article antimicrobial stewardship in the United Kingdom is discussed. Interview with: Tariq Azamgarhi, MRPharmS, PGDip Clin Pharm, PG CEPIP Interview by: Timothy P. Gauthier, Pharm.D., BCPS, BCIDP Article posted 1 August 2022 Antibiotic use and resistance varies geographically, but across the world antimicrobial stewardship (AS) and … [Read more...]
5 Important Things to Know About Stenotrophomonas maltophilia – The Nosocomial Nightmare Or A Complacent Colonizer?
In this article an infectious diseases pharmacist discusses five things to know about Stenotrophomonas maltophilia. Authored by: Hunter O. Rondeau, Pharm.D Article posted 9 July 2022 I remember the first time hearing the name Stenotrophomonas. At first, I thought a discussion about a Greek philosopher or new dinosaur was taking place. The medical … [Read more...]
Five Things I Learned From #ASMicrobe 2022 – Through Twitter
In this post an infectious diseases pharmacist identifies and discusses 5 things learned from #ASMicrobe 2022 - through Twitter Authored by: Timothy P. Gauthier, Pharm.D., BCPS, BCIDP Article posted 13 June 2022 There are many scientific meetings to go to these days. For infectious diseases enthusiasts, just a few that come to mind include IDweek, … [Read more...]